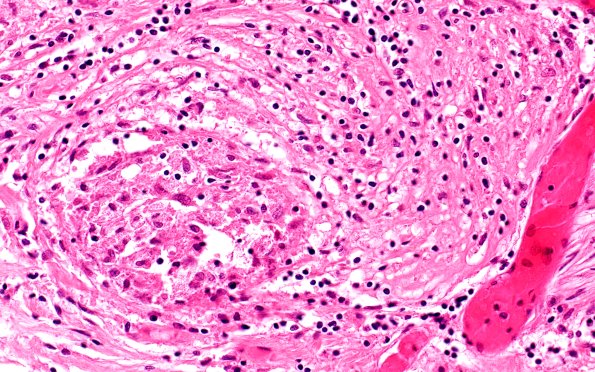
4B4 Neurosarcoid NP (Case 4) H&E 40X

Table of Contents
Washington University Experience | PERIPHERAL NEUROPATHY | 9A SARCOID | 4B4 Neurosarcoid NP (Case 4) H&E 40X
Higher magnifications of the root identified by an arrow in image #B1. The granulomas are accompanied by a lymphocytic infiltrate. (H&E)